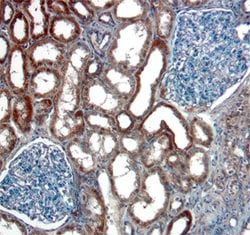

AF13417
19490-91-6 | Diphenyl-pyridin-3-yl-methanol
Manufacturer: A2B Chem
CAS Number: 19490-91-6
Select a Size
| Pack Size | SKU | Availability | Price |
|---|---|---|---|
| 100mg | AF13417-100mg | In Stock | ₹ 3,560.00 |
| 250mg | AF13417-250mg | In Stock | ₹ 7,120.00 |
| 1g | AF13417-1g | In Stock | ₹ 15,575.00 |
| 5g | AF13417-5g | In Stock | ₹ 61,855.00 |
AF13417 - 100mg
In Stock
Quantity
1
Base Price: ₹ 3,560.00
GST (18%): ₹ 640.80
Total Price: ₹ 4,200.80
Catalog Number
AF13417
Chemical Name
Diphenyl-pyridin-3-yl-methanol
Cas Number
19490-91-6
Molecular Formula
C18H15NO
Molecular Weight
261.3178
Mdl Number
MFCD02929154
Smiles
C1=CC=C(C=C1)C(C2=CC=CC=C2)(C3=CN=CC=C3)O
Other Options
| Image | Product Name | Manufacturer | Price Range | |
|---|---|---|---|---|
 | Diphenyl-Pyridin-3-yl-methanol | ChemScene | -- |